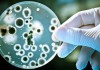
Govt Job – Dairy Chemist & Bacteriologist Openings @ KCMMF

Get Salary of Upto Rs 67,000/- as Professor / Assistant Professor / Associate Professor...
National Institute of Technology Rourkela,formerly Regional Engineering College Rourkela (REC Rourkela), is a publicly funded institute of higher learning for engineering and technology located...
Researcher post vacant @ Jadavpur University | Project – Study of Cancer cell line
Founding members of National Council of Bengal, the parent body of the Jadavpur University, in 1906 set the goal "To achieve self reliance through...
Govt Job – Dairy Chemist & Bacteriologist Openings @ KCMMF
Kerala Co-operative Milk Marketing Federation (KCMMF) was formed in 1980 as a state adjunct of the National Dairy Programme ‘Operation Flood’. It is a...
Join R&D Dept of Pepsico | Vacancy in Cereal & Pulses Extrusion process
PepsiCo products are enjoyed by consumers one billion times a day in more than 200 countries and territories around the world. PepsiCo generated more...
The first ever women owned biotech start-up
In conversation with Gayathri Thankachi and Aardra Chandra Mouli, Founders, Aeka Biochemicals Pvt. Ltd.
Promoting women entrepreneurship, green solutions and development of eco-friendly techniques are on their agenda...
Official Notification for Jawaharlal Nehru University Entrance Examination [ JNUEE ] 2016 – 2017
JAWAHARLAL NEHRU UNIVERSITY
Admission Announcement : 2016-17
ADMISSION THROUGH ENTRANCE EXAMINATION
The University will hold Entrance Examination on May 16, 17, 18 and 19, 2016 for admission...
Indian Council of Medical Research, New Delhi Hiring Research Assistants
The Indian Council of Medical Research the apex body in India for the formulation, coordination and promotion of biomedical research, is one of the...
CFTRI, Mysore hiring NET-LS qualified candidates
CSIR-Central Food Technological Research Institute, abbreviated to CSIR-CFTRI, is one of the 40 national research laboratories in India, set up under the aegis of...
Attention CSIR Aspirants | CSIR Fellowship has been revised
Council of Scientific & Industrial Research
(Human Resource Development Group)
CSIR Complex, Library Avenue, Pusa, New Delhi —110 012
No. 6/Fel lowship(ENH)/2k16/EMR-I - Office Memorandum
Sub.: Revision of...
Notification for Combined Biotechnology Entrance Exam 2016 – 2017
COMBINED BIOTECHNOLOGY ENTRANCE EXAMINATION FOR ADMISSION
TO M.SC. (BIOTECHNOLOGY); M.SC.(AGRI.) BIOTECHNOLOGY/M.V.SC. & M.TECH. (BIOTECHNOLOGY) PROGRAMMES
Admission Announcement : 2016-17
On behalf of the participating Universities,...
Biggest Biotech Fraud of 2015! Martin Shkreli- the bad guy of biotech
A very happy new year from the entire team of Biotecnika to its readers!
While another year unfolds with its blank pages to be filled...
Inauguration of “Global Technology Development Center” at Thermo Fisher Scientific
Interviewing:
Mr. Amit Chopra, Managing Director/VP, Thermo Fisher Scientific India
Mr. Manoj Prasad, Global Vice President, IT, Thermo Fisher Scientific
Mr. Ravi Shastri, MD, Life Science Solution,...
Ministry of Human Resource invites Applications for ‘2016 Korean Government Scholarship’
The essence of Human Resource Development is education, which plays a significant and remedial role in balancing the socio-economic fabric of the Country. Since...
Is CSIR really corrupt? Uncover the truth with Dr. Shiva Ayyadurai, Ex CEO, CSIR...
It has been two successful years since Biotecnika magazine has taken stage and after traversing for two years, our ardour to serve the biotech...
Apply for the The Novus Biologicals Scholarship Program – Get Paid Twice a Year
Accelerate Scientific Discovery by Developing Unique Products
The mission of Novus Biologicals, LLC is to accelerate scientific discovery by developing and marketing unique products for...


























![Official Notification for Jawaharlal Nehru University Entrance Examination [ JNUEE ] 2016 – 2017](https://www.biotecnika.org/wp-content/uploads/2016/03/banner1-324x235.jpg)